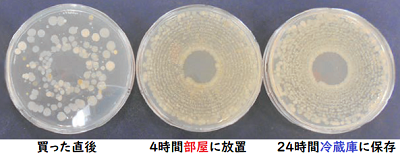
細菌培養した結果の写真。4時間部屋に放置したもの、24時間冷蔵をに保存したもの、いずれも細菌が増殖している。

暮らしに役立つ生活衛生情報誌「暮らし上手のヒントvol.9」

目次
- 自宅で行う消毒のポイント
- ジビエはシッカリ焼いておいしく食べよう!
- 「改葬」の手順と手続き
- 「食品衛生検査所」の残留農薬検査
- テイクアウトや宅配サービスを利用するときの注意点
- 消費期限と賞味期限の違い教えます!
- 年に一度の狂犬病予防注射
- 正しい手洗いで食中毒を防ごう!
1.お家ではじめる感染症対策!自宅で行う消毒のポイント
新型コロナウイルスの感染防止のため、消毒についての意識が高まっています。
ノロウイルスなど、その他の感染症対策のためにも、ご自宅で消毒を行うときのポイントを紹介します。


Q.どこを消毒すればいいの?
A.
手指がよく触れる場所を消毒しましょう。
<手指がよく触れる場所の例>
テーブル、机、イス、電話機、家電製品の取っ手、ドアノブ、手すり、電気のスイッチ類、洗面台や蛇口、トイレの便座や流水レバー等

Q.消毒の方法は?
A.
- 新型コロナウイルスには消毒用アルコール(70%から95%のエタノール)や次亜塩素酸ナトリウムが有効です。
(注)消毒用アルコールはノロウイルスには効果が薄いです。 - 汚れや水分を拭き取った後に、ペーパータオル等に十分薬液を含ませて拭いてください。次亜塩素酸ナトリウムの場合は、薬剤で拭いた後に水拭きしてください。
- スプレーボトルでの噴霧は、ウイルス飛散の可能性があるため好ましくありません。
- 「次亜塩素酸水(次亜塩素酸ナトリウムとは違います)」や家庭用洗剤の主成分である「界面活性剤」も一部有効です。消毒や除菌効果を謳う商品は、厚生労働省のホームページ(外部リンク)を参考に正しく選び、使用方法を守りましょう。

Q.消毒液の作り方は?(次亜塩素酸ナトリウムを薄める場合)
A.
- 一般的に「塩素系漂白剤」として販売されています。
- 製品の記載濃度をもとに、用途に応じて薄めて使用します。
- 手荒れの可能性があるため、手袋等を着用してください。
- 手指の消毒には使用しないでください。
- 消毒対象の材質によっては使えない場合がありますので、製品に記載された「使用上の注意」をよく読んでください。
≪塩素系漂白剤の希釈濃度と希釈方法≫
- ドアノブ、手すり等の消毒(濃度0.05%)
希釈方法(次亜塩素酸ナトリウム濃度約5%の場合)・・・500mlのペットボトル1本の水に塩素系漂白剤を5ml(ペットボトルのキャップ1杯)入れます。 - おう吐物が付着した床などの処理(濃度0.1%)
希釈方法(次亜塩素酸ナトリウム濃度約5%の場合)・・・500mlのペットボトル1本の水に塩素系漂白剤を10ml(ペットボトルのキャップ2杯)入れます。

2.寄生虫や細菌感染を防ぐため、ジビエはシッカリ焼いておいしく食べよう!
最近話題のジビエ。興味はあるけどよくわからない人も多いのでは?
ジビエは生食や加熱が足りないまま食べると大変危険です!ジビエをよく理解して、安全に美味しく食べましょう。

Q.「ジビエ」ってなに?
A.
ジビエとは狩猟で得た野生鳥獣の食肉を意味するフランス語。日本では捕獲数や農作物被害の多いシカやイノシシが有名ですが、狩猟の対象となっている野生鳥獣は全てジビエとして定義されています。
<ポイント>
- 野生動物なので、捕獲されるまで家畜のように管理されたえさや環境で育てられたものではありません。
- ジビエは、寄生虫やE型肝炎ウイルス、腸管出血性大腸菌などを保有していることがあります。

Q.安全に食べるためには?
A.
寄生虫や細菌感染を防ぐため、十分に加熱して食べるようにしてください。
生食、レア焼は大変危険です。絶対にやめましょう!

<ポイント>
- 肉は十分に加熱する。中心部分の温度が75℃1分以上となるように
- 生肉を触った後は丁寧に手を洗う。
- 生肉を扱ったまな板や包丁は、その都度洗剤で洗い、熱湯や塩素系漂白剤、アルコールで消毒!

3.お墓のお引越し「改葬」の手順と手続き
「改葬」とは、すでに墓地や納骨堂に埋蔵、収蔵されている遺骨を他の墓地や納骨堂に移すことをいいます。
「改葬」には、どのような手続きが必要なのでしょうか。

「改葬」には役所の手続きが必要です。
現在の墓地・納骨堂から遺骨を引き取る時、改葬先の墓地・納骨堂に遺骨を移す時に「改葬許可証」が必要となります。
現在、遺骨を納めている墓地・納骨堂の所在地が福岡市内であればその区の生活環境課で手続きを行います。
次の場合、改葬許可証は発行できないことがあります。
- 改葬先が決まっていない場合
- 改葬先の墓地や納骨堂が自治体から経営許可を受けていない場合
詳しくは各区生活環境課にご相談を。

手続きはどのように進めたらいいの?(福岡市の場合)
- 福岡市ホームページもしくは区役所窓口(生活環境課)で「改葬許可申請書」を入手し、必要事項を記載する(2部)。

- 現在遺骨を納めている墓地・納骨堂管理者へ改葬することを伝え、改葬許可申請書に「埋(収)蔵証明」を受ける(2部)。

- 現在遺骨を納めている墓地・納骨堂のある区役所窓口(生活環境課)で申請する。

- 「改葬許可証」を受け取ったら、現在遺骨を納めている墓地・納骨堂の管理者に提示し、遺骨を引き取る。その後、改葬先の墓地・納骨堂の管理者に改葬許可証を渡し埋(収)蔵する。

コラム
自宅に遺骨を置いておくときも、事前に「埋(収)蔵証明」を。
「手軽に供養できる」「故人を身近に感じられる」などの理由で、墓地・納骨堂ではなく自宅にて遺骨を管理される方もいます。
これは、次の改葬先が見つかるまでの一時保管扱いになるため、自宅で遺骨管理する際は事前に改葬許可申請書に現墓地・納骨堂管理者の埋(収)蔵証明を受けておきましょう。

4.ベジフルスタジアム内「食品衛生検査所」の残留農薬検査
福岡市東区にある青果市場「ベジフルスタジアム」内にある「食品衛生検査所」。
安全な野菜や果物等をみなさんに届けるためどんな役割を担っているのか、ご紹介します。

Q.食品衛生検査所って何をやってるの?
A.
青果市場内の巡回指導や市場内青果物の検査を通して“食の安全を守る役割”を担っています。
・市場が開いている日には食品衛生監視員が毎朝市場内を巡回し、カビ・腐敗した青果物や有毒植物の排除、衛生的な取扱いの指導及び食品表示の確認を行っています。
・市場に出荷された青果物を「せり」が始まる前に抜き取り、残留農薬や食品添加物(防かび剤)などの検査を行っています。

Q.どれくらい検査しているの?
A.
| 野菜 | 果物 | 合計 | |
|---|---|---|---|
| 国産 | 1,594 | 384 | 1,978 |
| 輸入 | 360 | 265 | 625 |
| 合計 | 1,954 | 649 | 2,603 |
品種(キャベツやトマトなど)や産地、旬を考慮しながら検査をする青果物を選定しています。
検査の結果、食品衛生法の基準に違反していた場合には、関連する事業者や自治体等へ、回収や原因究明及び再発防止などを依頼します。

実際に見よう!行こう!ベジフルスタジアム
ベジフルスタジアムでは、市場が休みの日を除き毎朝7時から行われる「せり」を見ることができるほか、残留農薬などの検査の様子もガラス越しに見ることができます。検査の様子を間近に見学できる施設は珍しく、必見です。
コラム
農薬には、主なものに「殺虫剤」や「除草剤」などがありますが、「天敵」といった虫も農薬に含まれます。
「天敵」
農作物を食べたりしてしまう害虫を捕食する生物のこと。
アブラムシを捕食するテントウムシなどが利用されています。

5.食中毒を防ぐため、テイクアウトや宅配サービスを利用するときの注意点
テイクアウトや宅配では、調理された食品を食べるまでの時間が長くなるため、細菌が増加して食中毒のリスクが高まります。
利用する際の注意点を守って、食中毒を防止しましょう。

気をつけよう!5つのポイント
- 購入・注文するとき
・すぐに食べきれる量を購入・注文する。
・表示がある食品は、消費期限や保存方法の表示を確認する。(表示がない場合は、お店の人に確認する。)
- テイクアウトするとき
・買い物の最後に食品を購入し、長時間持ち歩かない。
・保冷剤を活用する。(保冷バッグで効果UP!)
- 宅配を受け取るとき
・家にいるときに受け取れるよう手配する。
・異常を感じたら、すぐに購入先に相談する。(要冷蔵品が冷えていない、容器が破損している、など)
- 食べるとき
・食べる前には必ず手を洗う。
・すぐに食べきる。
・すぐに食べられない場合は冷蔵庫に保存し、食べる前は中心部分まで十分に加熱する。
・傷んでいるなどの異常を感じた場合は食べない。
- 調理されていない「鍋セット」などの半製品を購入するとき
・保存方法や消費期限を表示で確認する。
・適切な方法で保存し、消費期限内に十分加熱調理し食べる。
コラム
すぐに食べないと細菌が増加する場合があり、注意が必要です!
サラダパスタによる実験(白色や黄色い斑点が細菌です)

6.食品を安全に食べよう!消費期限と賞味期限の違い教えます!
食品に記載されている期限の表示には、消費期限と賞味期限の2つがあります。
その違いを正しく理解することで、食品を安全に食べられる期限を知りましょう。

Q.「消費期限」 「賞味期限」って?
A.
| 消費期限 | 賞味期限 | |
|---|---|---|
| 定義 | 安全に食べられる期限 (消費期限が切れた食品は食べないようにしてください。) |
品質が変わらずおいしく食べることができる期限 (賞味期限を過ぎても、すぐに食べることができなくなるということではありません。) |
| どんな 食品に |
品質が急速に劣化する食品に用いる | 比較的品質が劣化しにくい食品に限る |
| 例 | 弁当、サンドイッチ、生菓子等 | スナック菓子、カップめん、缶詰等 |


Q.消費期限と賞味期限はどうやって決めているの?
A.
製造者等が科学的、合理的な根拠に基づいて設定しています。
食品の特性に応じて、安全性を考えに入れた消費期限と賞味期限の設定を行っています。

Q.ふたや包装を開けてしまったら?
A.
消費期限と賞味期限は、ふたや包装を開けずに食品に記載されている保存方法を守った場合、安全においしく食べることのできる期限です。
一度開封した食品は、表示されている期限に関係なく早めに食べるようにしましょう。

コラム
「消費期限」 「賞味期限」が書かれていない食品もあります。
品質の劣化が極めて少ない食品は期限の表示を省略することができます。
塩、砂糖、うまみ調味料、でん粉、アイスクリーム等は期限の表示が省略されていることがあります。

7.大切な愛犬と人の命を守るため、年に一度の狂犬病予防注射
狂犬病の予防注射は、飼い犬に年に1回、4月1日から6月30日までの間に接種してください。
福岡市では、犬の登録を行っている飼い主に毎年狂犬病予防集合注射の会場等に関する通知を行っています。

Q.人も狂犬病にかかるの?
A.
主に狂犬病に感染した犬に咬まれることで感染します。発症するとほぼ100%死亡するとても怖いウイルス性の感染症です。
Q.日本で発生事例はあるの?
A.
日本では60年以上狂犬病が発生していません。しかし、海外では毎年約5万人が狂犬病で死亡しています。
2020年、海外で犬に咬まれた人が日本に入国し、狂犬病で死亡する事例が起きています。

愛犬そして人の命を守るためには
- 室内飼育の犬でもしっかり予防
日本では発生がなくても海外から侵入した動物によりウイルスが広がる可能性があります。飼い方にかかわらず犬の登録と狂犬病の予防注射は必ず行いましょう!
- 海外では動物に近寄らない
海外のほとんどの国では、犬、猫のほか、キツネやアライグマなどの野生動物も狂犬病の感染源となっています。犬や猫だけでなく野生動物にも不用意に近づかないようにしましょう。
狂犬病の予防注射の会場について
狂犬病の予防注射は最寄りの動物病院、動物愛護管理センターまたは狂犬病予防集合注射会場で受けられます。
くわしくは福岡市から犬の飼い主(登録者)の住所宛に送付している通知はがきをご確認ください。通知はがきが届かない場合は下記連絡先で登録についてご確認ください。
・ 家庭動物啓発センター(電話番号: 092-891-1231 )
・ 東部動物愛護管理センター(電話番号: 092-691-0131 )

コラム
鑑札と注射済票の装着も飼い主の義務です!
登録は一度の手続きで生涯有効な犬の戸籍です。
登録時に交付された「鑑札」は狂犬病予防注射後に交付される「狂犬病予防注射済票」と一緒に飼い犬に装着しておきましょう。鑑札・注射済票は、犬が迷子になったときや、災害時離れ離れになったときも迷子札として役立ちます。


8.ノロウイルスの感染に要注意。正しい手洗いで食中毒を防ごう!
おう吐や下痢を主症状とするノロウイルスによる食中毒や感染症。
年間を通して注意が必要ですが、特に冬は流行するため、予防対策が大切です。

Q.ノロウイルスとは?
A.
感染性胃腸炎の原因のひとつです。
感染すると通常1から2日後に症状が出てきます。
患者のおう吐物やふん便中には大量のウイルスが含まれており、症状がなくなっても2週間程度、長くて1ヶ月程度はウイルスがふん便中に含まれるため、他の人に感染させる可能性があります。

Q.どうやってうつるの?感染経路は?
- ウイルスに汚染された二枚貝などを、生または十分に加熱せずに食べて感染。
- ウイルスに感染した人が、排便後の手洗いが不十分なために食品を汚染し、その食品を食べて感染。
- ウイルスを含むふん便やおう吐物の処理の際に適切な処理や消毒をせずに感染。

ノロウイルス食中毒の多くは、手を介してウイルスが食品に付着することで起こります。正しい手洗いで食中毒を予防しましょう。
正しい手洗いの4つのステップ
- 指輪・時計などを外し、流水で汚れを洗い流します。

- 手洗いせっけんをつけ、しっかりと泡立て、手のひらをよくこすります。

- 手の甲や指の間、親指の周り、指先や爪、手首を洗います。

- 流水で十分にすすぎ、清潔なタオルやペーパータオルで拭きます。


コラム
「消毒」や「加熱」も大切な予防のひとつです。
- 消毒には熱湯又は市販の「家庭用塩素系漂白剤」に含まれる次亜塩素酸ナトリウムが有効です。
(注)ノロウイルスにアルコールは効果が薄いです。 - ウイルスを含むおう吐物などは次亜塩素酸ナトリウムを使って確実に処理しましょう。
- 食材はよく加熱しましょう。
詳しくは、1.自宅で行う消毒のポイントへ

「暮らし上手のヒント」他の号も読みたい方はこちら



 東区
東区 博多区
博多区 中央区
中央区 南区
南区 城南区
城南区 早良区
早良区 西区
西区